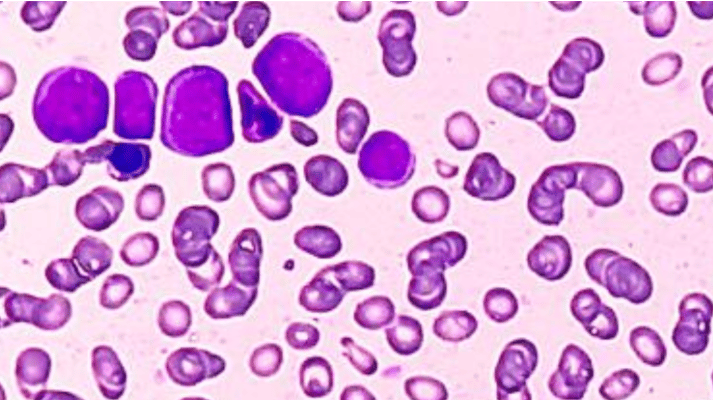

“Season's Greetings from Huck Institutes!”
As we wrap up an incredible year of research and collaboration, this issue is packed with stories that showcase the strength and creativity of our community. Just a few of these include:
How stress may lead to altered blood flow in the brain, offering new insights into neurobiology.
The launch of a new Neurobiology major, opening doors for future scientists.
Celebrating six Huck faculty named to Clarivate’s Highly Cited Researchers list.
Huck researchers earning College of Agriculture awards for outstanding contributions.
Innovative work turning fermentation waste into natural fibers, advancing sustainability.
Plus, don’t miss the Huck Pop-Up Shop—order your Huck gear through December 14 and show your pride in style!
And because the holidays are all about sharing and celebrating together, join us for a festive gathering:
Holiday Treat Exchange, December 17, 11:30 AM – 1:30 PM, 4th Floor Bridge, Huck Life Sciences Building
Bring your favorite holiday treats to share and enjoy a sweet break with friends and colleagues. Let’s wrap up the year with good cheer and great company!
Click here to shop the Huck Institutes Pop-Up Shop. Available through December 14.

Strategic Research
Feature Story
The type of neuron the team targeted, type-one nNOS, which is colored yellow in the figure above, is rare compared to other neurons in the brain. By using the injection method, the team was able to systematically eliminate these neurons from the brain, providing insight into the role they play.
While the exact causes of neurodegenerative brain diseases like Alzheimer's and dementia are still largely unknown, researchers have been able to identify a key characteristic in affected brains: reduced blood flow. Building upon this foundational understanding, a team at Penn State recently found that a rare neuron that is extremely vulnerable to anxiety-induced stress appears to be responsible for regulating blood flow and coordinating neural activity in mice.
“In your brain, arteries, veins and capillaries help move fluid around by constantly dilating and constricting every few seconds, which we call spontaneous oscillation. Previous work from our lab has shown that nNOS neurons are important for regulating blood flow in the brain. After targeting and eliminating a subset of these neurons, we observed a significant reduction in the amplitude of these oscillations.”
The researchers found that eliminating type-one nNOS neurons — which make up less than 1% of the brain’s 80 billion neurons and die off when exposed to too much stress — resulted in a drop in both blood flow and electrical activity in mice brains, demonstrating the impact this neuron type has on the proper brain functions of animals, including humans.
The team published their research Nov. 11 in eLife.
Penn State Professor Melik Demirel, to the far right, his students and their families wear biomanufactured sweaters.
A fermentation byproduct might help to solve two major global challenges: world hunger and the environmental impact of fast fashion. The leftover yeast from brewing beer, wine or even to make some pharmaceuticals can be repurposed to produce high-performance fibers stronger than natural fibers with significantly less environmental impact, according to a new study led by researchers at Penn State and published in the Proceedings of the National Academy of Sciences.
The yeast biomass — composed of proteins, fatty molecules called lipids and sugars — left over from alcohol and pharmaceutical production is regarded as waste, but lead author Melik Demirel, Pearce Professor of Engineering and Huck Chair in Biomimetic Materials at Penn State, said his team realized they could repurpose the material to make fibers using a previously developed process. The researchers successfully achieved pilot-scale production of the fiber — producing more than 1,000 pounds — in a factory in Germany, with continuous and batch production for more than 100 hours per run of fiber spinning.
Acute myeloid leukemia, pictured here, is a cancer of blood and bone marrow that can affect people of all ages but is the most common type of leukemia in adults. Credit: Salah Uddin/Getty Images. All Rights Reserved.
Two U.S. Food and Drug Administration (FDA)-approved drugs for treating prostate cancer may also be effective against acute myeloid leukemia (AML), according to a new study by researchers at Penn State. AML, a cancer of blood and bone marrow, can affect people of all ages but is the most common type of leukemia in adults.
The research, recently published in the journal Blood Advances, tested the ability of the two drugs — apalutamide and finasteride — to treat leukemia in experimental models. They found that the drugs were effective in treating mice with AML as well as patient-derived AML cells.
Eating moderate amounts of lean beef as part of a Mediterranean diet does not increase an emerging risk factor for cardiovascular disease, according to a new study by an interdisciplinary research team at Penn State.
The researchers examined indicators of heart health and gut microbiome diversity among relatively young and healthy participants who ate four different diets, including varying amounts and types of beef, for four weeks.
To see how microbial activity changes near and inside roots, the researchers chose crimson clover, or Trifolium incarnatum, as a test plant. It’s a legume commonly grown as a cover crop in the U.S. Northeast that forms root nodules with bacteria like the one shown here.
Soil microbes benefit plants by helping with nutrient uptake and disease resistance. Modulating these communities of bacteria and fungi could potentially sustainably improve agriculture, according to the Food and Agriculture Organization of the United Nations. But a major obstacle to this approach has been that many of these microbes are dormant, or inactive, in the soil — and microbes must become active to colonize plant roots, moving into and living inside plant tissues.
Until now, it hasn’t been clear how dormancy affects which microbes make it into a plant, but in a new study using a novel technique, a team of researchers at Penn State found that a microbe’s activity appears to matter more than abundancy.
Accolades & Awards
Penn State’s College of Agricultural Sciences recognized exceptional achievements in research during its fourth annual Research Awards Ceremony held Oct. 28 at the Hintz Family Alumni Center on the University Park campus.
🏅 Interdisciplinary Research Team Award
The BeeSuite Research team received the Interdisciplinary Research Team Award for integrating expertise in entomology, agroecology, data science and stakeholder engagement to study pollinator populations in changing environments.
Led by Christina Grozinger, Publius Vergilius Maro Professor of Entomology and director of the Huck Institutes of the Life Sciences, the team includes:
Anthony Robinson, professor of geography and director of Online Geospatial Education Programs at Penn State
Heather Grab, assistant professor of entomology
Dave McLaughlin, research and development engineer in the Penn State Institute for Computational and Data Sciences
Collaborators at other institutions, including the U.S. Department of Agriculture-Agricultural Research Service, the University of Pittsburgh, Emory University, Dickinson College and EcoData Technology.
The team develops interactive decision-support tools — Beescape, BeeSpatial and BeeWinterwise — to help growers, beekeepers, conservationists and policymakers forecast how climate and land use affect pollinators and crop yields.
🏅 Early Achievement in Research Award
Liana Burghardt, assistant professor in the Department of Plant Science, received the Early Career Research Achievement Award. Burghardt holds the Dorothy Foehr Huck and J. Lloyd Huck Early Career Chair and directs the Huck Center for Root and Rhizosphere Biology.
Her research explores ecological and evolutionary processes behind legume-rhizobia interactions to enhance agricultural sustainability.
She has secured nearly $4 million in funding from the U.S. Department of Agriculture, the National Science Foundation and the Department of Energy. Burghardt received the International Tansley Medal for Excellence in Plant Science and leads a collaborative team studying the genomics of nitrogen-fixing bacteria and plant-microbe relationships.
Top row: Jordan Bisanz, Long-Qing Chen, Huanyu Cheng || Bottom row: Daniel Cosgrove, Francisco Dini-Andreote, Andrew Patterson
According to Clarivate, of the world’s population of scientists and social scientists, Highly Cited Researchers are 1 in 1,000. Six Huck Institutes of the Life Sciences researchers have been recognized in the 2025 list:
Jordan Bisanz, assistant professor of Biochemistry and Molecular Biology
Long-Qing Chen, advisor for the Center for Mathematics of Living and Mimetic Matter
Huanyu Cheng, associate professor of Engineering Science and Mechanics
Daniel Cosgrove, Eberly Chair and professor of Biology
Francisco Dini-Andreote, Huck Early Career Chair in Microbial Community Ecology, associate professor of Plant Science
Andrew Patterson, associate director, Huck Institutes of the Life Sciences, professor and Huck Chair of Molecular Toxicology.
Highly Cited Researchers demonstrate significant and broad influence in their field(s) of research. Each researcher selected has authored multiple Highly Cited Papers which rank in the top 1% by citations for their field(s) and publication year in the Web of Science Core Collection over the past eleven years. However, citation activity is not the sole selection indicator. This list, based on citation data, is then refined using other quantitative metrics, as well as qualitative analysis and expert judgment.
Undergraduate Education
Zhaoyang Jiang, Biology Ph.D. candidate, records ion channel activity in a living cell with Timothy Jegla, associate professor of biology.
The Penn State Eberly College of Science is launching a new major in neurobiology, a degree that will prepare students to tackle the cross-disciplinary questions and problems related to the brain, the nervous system and its interactions with the body and environment, and brain health. The Bachelor of Science in Neurobiology will provide a comprehensive framework of training to fill an increasing student interest and need for wide-ranging skillsets in neuroscience research, preparation for medical and healthcare careers, and beyond.
“This new degree in Neurobiology provides a key steppingstone for our students toward becoming a neuroscience researcher or preparing for various careers in health and medicine. Our faculty in the neurobiology degree are doing ground-breaking research into the neurological basis of aging disorders, autism, addiction, sleep, learning and memory, providing undergraduate students with the opportunity to take their degree out of the classroom and into the lab, and the addition of this major will allow us to further offer competitive training in line with our Big Ten and regional Pennsylvania peers.”
The Penn State Faculty Senate approved the new degree program this summer, with plans to enroll students starting the 2025-2026 academic year. Explore the undergraduate neurobiology major on Eberly's website.
Key Papers
Working definition of a microbiome. Using an extended metaphor, a microbiome can be described as a theater where microorganisms and viruses (actors) perform a play.
Led by Penn State’s Estelle Couradeau, assistant professor of soils and environmental microbiology, researchers from the Food and Agriculture Organization of the United Nations (FAO), one of the four organizations in the "Quadripartite" group that developed the One Health Joint Plan of Action (OHJPA), successfully advocated to include microbiomes into the OHJPA.
Learn more about this collaborative, international research in mBio.
Upcoming Events
Ensuring Sustainable Bioenergy and Biomaterials for People and the Planet
🗓️ December 5 @ 8 AM - 5 PM 📍HUB-Robeson Center, Heritage Hall
The Penn State Postdoc Research Symposium is back for its 18th year to showcase postdoctoral research across all disciplines! Hosted by the Office of Postdoctoral Affairs, this exciting event offers:
Short Talks & Poster Sessions
Work in Progress Welcome! Share early ideas, ongoing projects, or recently presented work
Prizes for Outstanding Presentations
Networking with Faculty, Peers & Mentors
Holiday Treat Exchange
🗓️ December 17 @ 11:30 AM - 1:30 PM 📍4th Floor Bridge, Huck Life Sciences Building
Bring your favorite holiday treats to share and enjoy a sweet break with friends and colleagues. Let’s wrap up the year with good cheer and great company!
For the most up-to-date events, seminars, and symposiums, visit huck.psu.edu/events
Huck in the News
Huck research attracts media attention from around the world. Here are some highlights from the past month:
Cross-ancestry study explains why obesity risks differ around the world [News-Medical]
New research challenges common heart health myths [SciTechDaily]
Doctors discover how stress can damage brain cells [Star Local Media]
Do you have an important or impactful story to share? Have something to celebrate? Let us know by emailing [email protected].